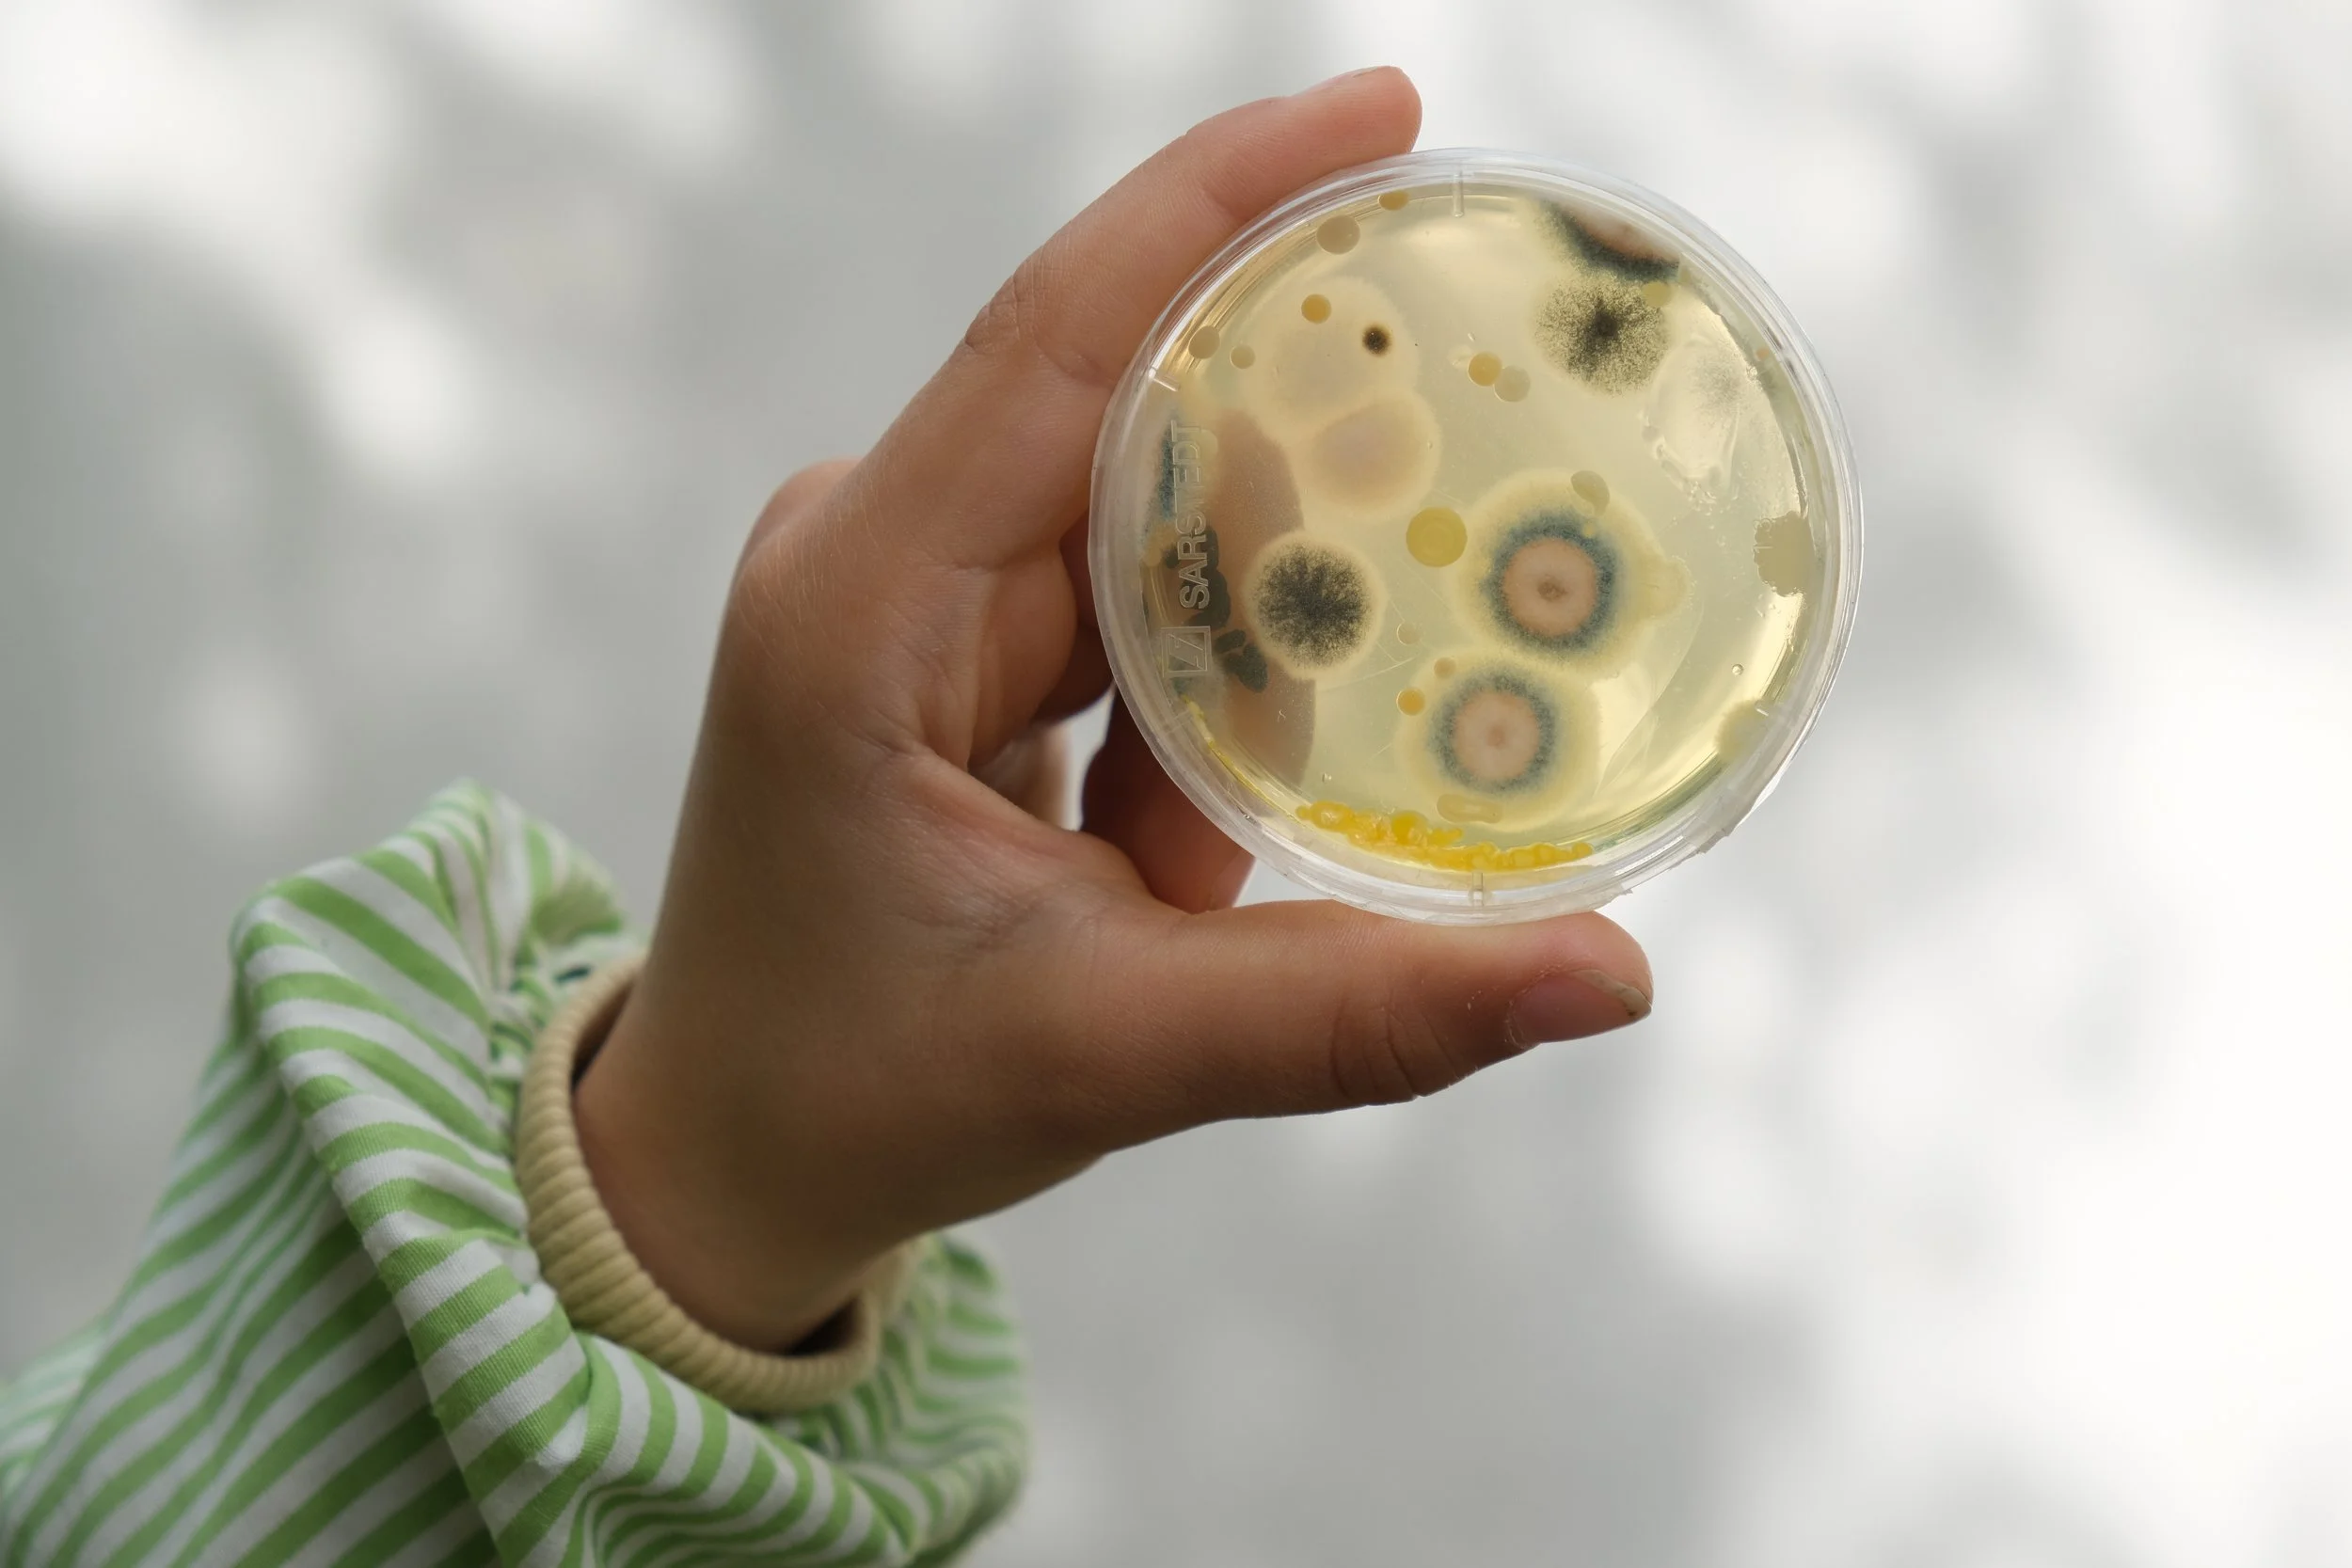

Intervenção em Espaço Público
Nesta secção apresentamos uma seleção de projetos de intervenção em espaço público desenvolvidos pela OSMOPE, em trabalho colaborativo e interdisciplinar, em articulação com diferentes áreas e com diversos parceiros externos. Tratam-se de processos coletivos onde crianças, educadores, artistas e investigadores exploram o espaço como lugar de investigação, expressão e participação.
Os projetos aqui apresentados foram partilhados, divulgados e expostos em museus ou outros espaços públicos, reforçando a ligação entre escola, cidade e comunidade. São experiências que revelam a postura da OSMOPE em relação com o exterior — aberta ao diálogo, à cidadania e à construção de pontes entre educação, cultura e vida pública.
Cota 1,20
2021-2023
Este projeto explorou a relação das crianças com a Rua Mouzinho da Silveira, no Porto. Envolveu profissionais de diversas áreas de formação, e culminou em exposições no MNAC - Museu Nacional de Arte Contemporânea (Lisboa, Chiado), e no MHNC-UP Museu de História Natural e da Ciência da Universidade do Porto.

Há um ditado popular que diz “Não se pode amar aquilo que não se conhece”. Esta razão afetiva já é uma boa razão para partir à descoberta.
Olhorelho
2023
Olhorelho, quando a arte cinematográfica desafia as crianças na produção de novos discursos
A arte cinematografica tem demonstrado ser uma das areas que muito tem contribuído para a desenvolvimento de novas práticas educativas ao nível não só da construção da narrativa, como também na apreciação e exploração estética, gráfica e sonora, num tempo em que o ruído visual e auditivo invade sistematicamente a vivência quotidiana das nossas crianças.




A Escola deve promover a capacidade de desvendar o mundo, de o interrogar, de o envolver.
microMacroMundo
2022-2024
Este projeto desenvolveu-se a partir de uma parceria entre a OSMOPE, o i3S e a FBAUP, explorando a relação da Escola com a investigação Científica, mediada pelo Design, envolvendo profissionais de diversas áreas - científicas, artísticas e pedagógicas - e atuando diretamente em cerca de 200 crianças dos 3 aos 10 anos de idade.

A escola deve ser motor de uma cidadania ativa, de democraticidade, e com potencial de transformação do mundo.
AbrirAbril
2024-2025
AbrirAbril surge da necessidade de refletir, em espaço escola e de forma participada, sobre o pensamento democrático e livre conquistado em abril de 1974, relembrando a importância desta revolução.







